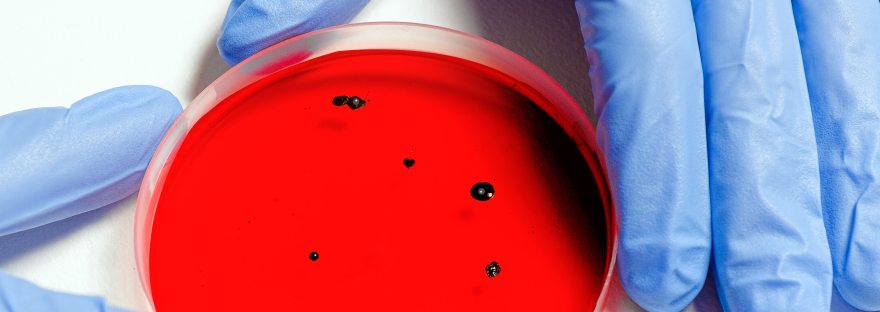

משירי ארץ אהבתי הוא מחזור של שלושה שירים מאת לאה גולדברג, הנקראים על פי מילות הפתיחה שלהם: א. מכורה שלי ב. בארץ אהבתי השקד פורח ג. בארץ אהבתי האביונה. מטרת פוסט זה להתמקד בשירה של לאה גולדברג "מכורה שלי" (1951) ולבחון את מושג המולדת, בית, עקירה וגעגועים תוך התייחסות לסוגיות העולות מהמציאות החדשה שפגשנו ב -7 אוקטובר. כמו כן, תוצג… להמשיך לקרוא "לתנות דלותך הזוהרת": בית שהוא געגוע לנוכח 7 באוקטובר: זיכרון, כאב ואובדן הבית
בית מדרש: מהי בחירה חופשית
כתבו וליקטו: גל עזרן ועליזה שחיבר וסרמן ספרו לקבוצה על בחירה אחת משמעותית שבחרתםן בשנה האחרונה. 70 פנים ליהדות: להלן 3 תפיסות של מושג הבחירה ביהדות. איזו בחירה הולמת את תפיסת עולמך? הַחַיִּים וְהַמָּוֶת נָתַתִּי לְפָנֶיךָ הַבְּרָכָה וְהַקְּלָלָה וּבָחַרְתָּ בַּחַיִּים" (דברים ל:יט). רבי חנינא: הכל בידי שמים חוץ מיראת שמים" (בבלי ברכות לג ע"ב) הַכּל… להמשיך לקרוא בית מדרש: מהי בחירה חופשית
איך מתחילים ללמד סיפור? חג מולד אחד – טרומן קפוטה
סיכום ארוך ומפורט על הסיפור ניתן למצוא במרחב הפדגוגי של הוראת הספרות: https://meyda.education.gov.il/files/Mazkirut_Pedagogit/sifrut/chagmoladyuvalpaz.pdf כמו כן, באתר ספרות וחיים של חגית טולדו https://www.canva.com/design/DAFvnHLK63I/Pjr_JONtGnN7-6_EI1Qlyg/view?utm_content=DAFvnHLK63I&utm_campaign=designshare&utm_medium=link&utm_source=publi המערך הבא מציע דרך הוראה לשיעור הראשון: 1.לבקש מהתלמידים לחפש בטלפונים האישיים 5 עובדות על טרמן קפוטה. 2. לרשום על הלוח את כל העובדות שהתלמידים הציגו או בלוח פדלט שהמורה תכין. 3. להקריא… להמשיך לקרוא איך מתחילים ללמד סיפור? חג מולד אחד – טרומן קפוטה
שקט / תשלח לי שקט – יונה וולך – שיעור פתיחה נכתב על-ידי רחל זילברג
קריאת השיר השמעה מידע - סיפור חייה של יונה וולך – מועד ונסיבות כתיבת השיר מושג - בין שיר (POEM) לפזמון (SONG) הפעלות תלמידים (בחירה מתוך אופציות) בחר/בחרי שורה מהשיר שאהבת/עניינה אותך/ הרגיזה אותך/ והסבר/הסבירי מדוע הוסף/הוסיפי שורה משלך לשיר. אופציה/החליפי אותה בשורה קיימת 'השיר שלנו' – כל תלמיד או שניים יקבלו שורה מהשיר ויתבקשו… להמשיך לקרוא שקט / תשלח לי שקט – יונה וולך – שיעור פתיחה נכתב על-ידי רחל זילברג
בית מדרש: מלחמה ונקמת דם ילד קטן
אנחנו שרויים בימי מלחמה ארוכים וכואבים. עת שמעוררת שאלות מוסריות בלתי פתירות ומעיקות. ביאליק ב"על השחיטה" מציג את הכוח של הנקמה בהתמודדותו של הפרט עם הרוע האנושי. דווקא, את הנקמה האנושית הוא שולל, ומציג את הגילגולים השונים של נקמה קוסמית, על-אנושית ואוליי אל-מותית. מתודת "בית מדרש" היא למידה שיתופית, תהליכית בין-תחומית. התלמידים מתכנסים כדי ללמוד… להמשיך לקרוא בית מדרש: מלחמה ונקמת דם ילד קטן
האומנם עוד יבואו ימים בסליחה ובחסד?
מהי תפיסת התקווה בשירה האייקוני של לאה גולדברג "האומנם" או "את תלכי בשדה"? הַאֻמְנָם עוֹד יָבוֹאוּ יָמִים בִסְלִיחָה וּבְחֶסֶד, וְתֵלְכִי בַּשָּׂדֶה, וְתֵלְכִי בּוֹ כַּהֵלֶךְ הַתָּם, וּמַחֲשׂוֹף כַּף-רַגְלֵךְ יִלָּטֵף בַּעֲלֵי הָאַסְפֶּסֶת, אוֹ שִׁלְפֵי-שִׁבֳּלִים יִדְקְרוּךְ וְתִמְתַּק דְּקִירָתָם.... בשנים האחרונות, השיר תוייג ונלמד כשיר שואה, וגם יש הטוענים שהשיר נכתב בהשראת הביוגרפיה של רוזה קורצ'אק. אולם, גבע (2013)… להמשיך לקרוא האומנם עוד יבואו ימים בסליחה ובחסד?
המדריך הקצרצר למטייל בטקסט הספרותי
עוד געגוע לקריאה ספרותית פורמיליסטית, לשיח ספרותי העוסק בדמות ספרותית, במבנה נרטיבי, במוטיב ובתחבולה אומנותית. נפתח בסיפור הקצרצר של אברי הרלינג "מבטו של האנטי-גיבור". לאחר הקראה של הסיפור, אפשר לבקש מהתלמידים לחלץ מהסיפור מושגים ספרותיים. אפשרות ראשונה, בקבוצות למידה, יוגדרו המושגים. אפשרות שנייה, בקבוצות למידה התלמידים יבחנו את עיצוב המושגים (ללא הגדרה טכנית) בסיפור חדש.… להמשיך לקרוא המדריך הקצרצר למטייל בטקסט הספרותי
בלילה
כתבה: איריס סורוקר הלילה הוא הזמן הזה ביממה שבו אנו מתכנסים לתוך עצמנו. יום נגמר, חשיכה ירדה, מחשבות פוקדות, רגשות צפים. האם נחלום חלום נעים? השיעור יוקדש להכרות ראשונית עם מוטיב הלילה בספרות. מהלך השיעור: פתיחה: ניתן לבחור בהשמעת/הקראת שיר (שיר מוצע להלן), או בהקרנת מצגת (להלן) .https://docs.google.com/presentation/d/16ZqBY_VVB2OpyU4jDB2OhZaGO9jg1Fc_/edit#slide=id.p1 השיר יוכל לשמש לחלופין לסיגור השיעור. נאזין… להמשיך לקרוא בלילה
דון קיחוטה (1605) ויצוגים ויזואליים
כתבה: חנה עופר דמותו של דון קיחוטה העסיקה אנשי רוח רבים מעת פרסומו בשנת 1605. ציירים בתקופות שונות העניקו פרשנויות שונות לדמותו: מסעותיו של אביר הנלחם בבלתי אפשרי, חלומות בהקיץ, שאיפה לתיקון עולם ועוד.במצגת מוצגות דמויות של דון קיחוטה וסנצ'ו פנסה בסגנונות ובפרשנויות שונות בהתאם לרוח הזמן ולהיבטים חברתיים בתקופות בהן צויירו. לדוגמה, אונרה דומיה… להמשיך לקרוא דון קיחוטה (1605) ויצוגים ויזואליים
דיון ביחסי אני-זולת במעבר מ"יונתן" ל"בובה ממוכנת": שילוב ריאיון ושיר של רביקוביץ' על וולך בהוראה
כתבה: גל עזרן על אף שחשובה ההבחנה בין הדובר השירי למשורר, ההפרדה בין היוצרת ליצירתה – שכן השירים עומדים הווים לבד בזכות עצמם ובכך מהווים יחידה עצמאית אוניברסלית להזדהות עימם – במקרה של הוראת השירים "יונתן" לוולך ו"בובה ממוכנת" לרביקוביץ', התייחסות לביוגרפיה של שתי המשוררת בבחינת שירטוט של מערכת היחסים ביניהן, עשויה לשרת את העמקת… להמשיך לקרוא דיון ביחסי אני-זולת במעבר מ"יונתן" ל"בובה ממוכנת": שילוב ריאיון ושיר של רביקוביץ' על וולך בהוראה